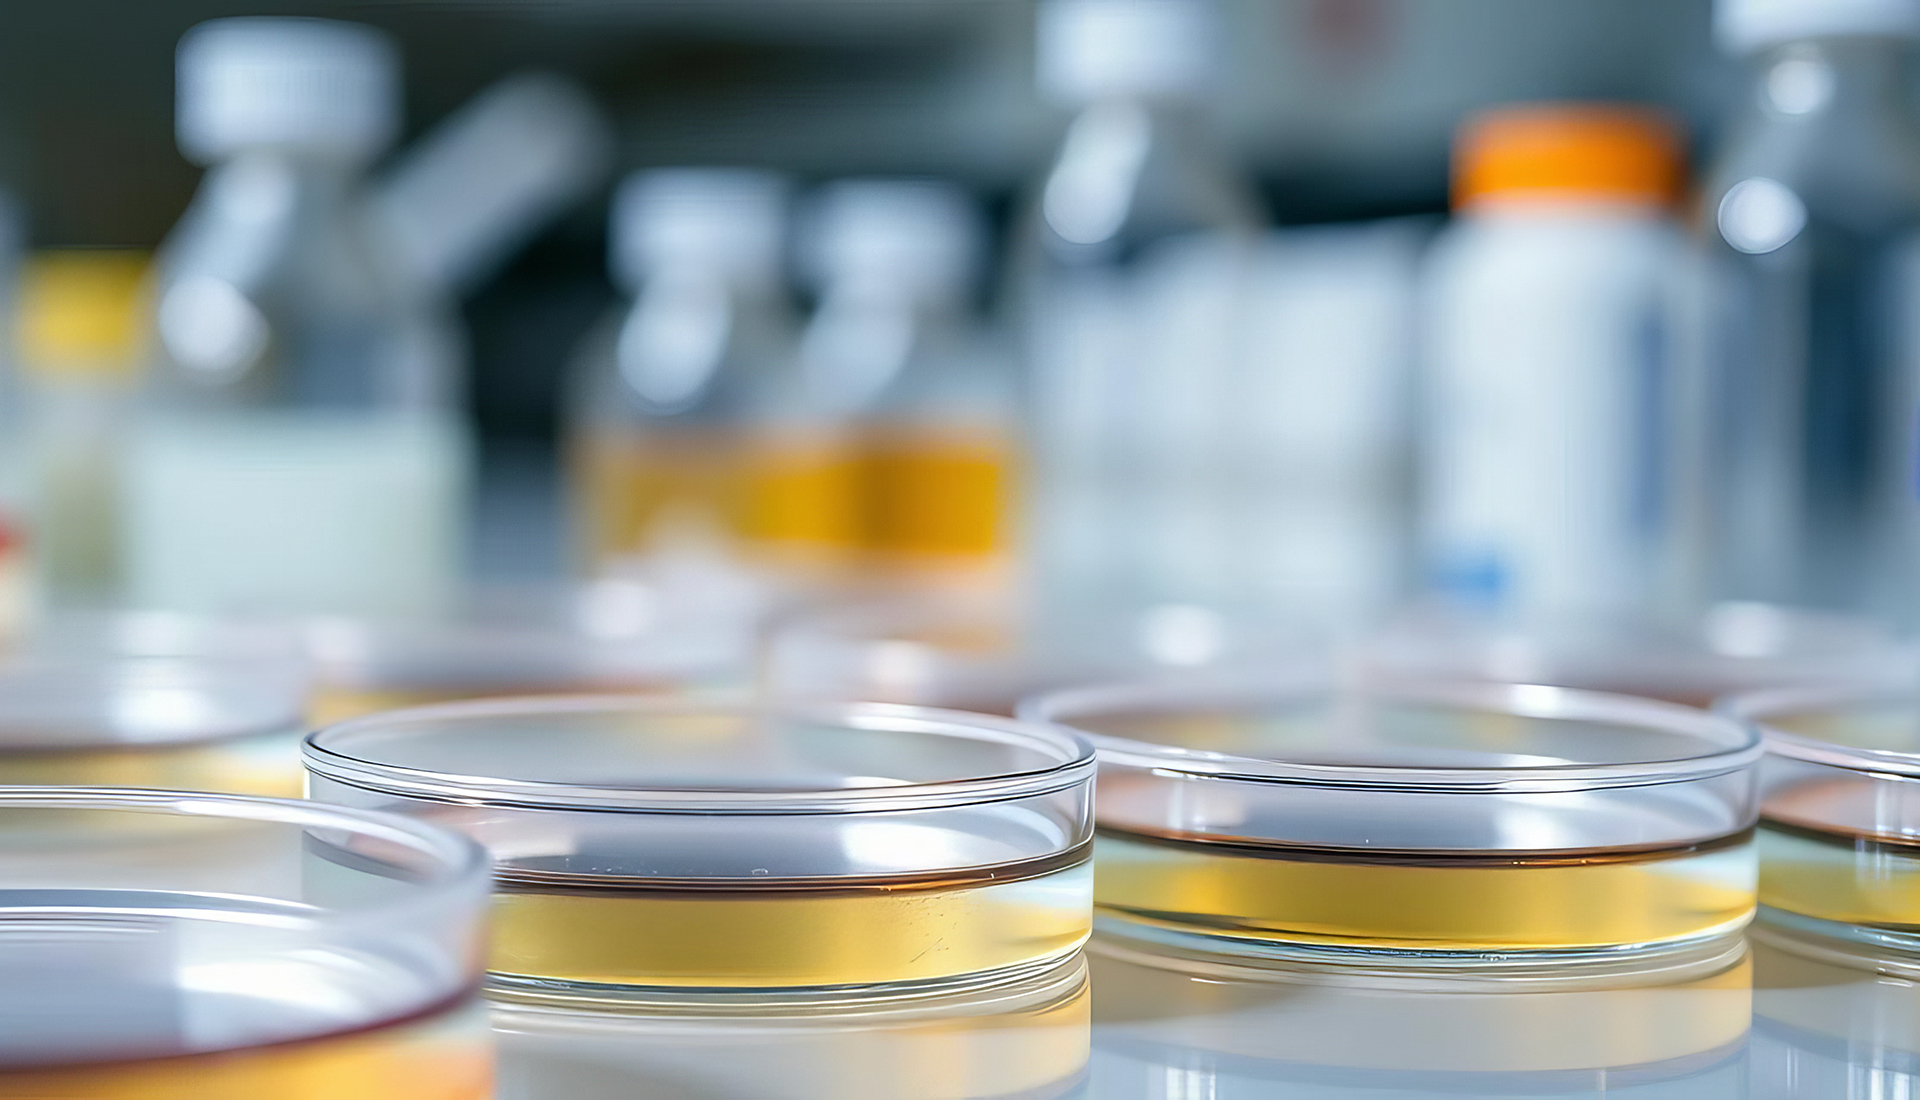

日本に初めて細胞培養加工施設が誕生して20年。
私たちは、地道なクライアントへの提案により再生医療・細胞治療の現場を
サポートして参りました。
臨床研究が着実に進む中、iPS細胞の発見と応用により、その管理・運営には、より高品質なものが必要とされています。弊社は、GMP施設の組織や文書の確立及び、運営管理の支援を通して、お客様の潜在的な課題解決に向けた様々なソリューションを提供出来るよう、取り組んで参ります。
製造設備機器・各種システムの設計・製作・消耗品販売

プロダクツ
従来からの設備機器や、当社オリジナル大量培養CO2インキュベータ「AC800」をラインナップ。また、施設運用の要である工程管理システムに至るまで…
導入事例
細胞培養加工施設における国内トップクラスの先端導入事例を多数掲載しております。施設全体のデザイン設計からシステム構築、運用方法に至るまで…

消耗品の販売
細胞培養加工施設において、日常業務で使用される消耗物品から、機器・空調等のメンテナンスで使用される交換部品等、幅広く取り扱っております。弊社オリジナル…

